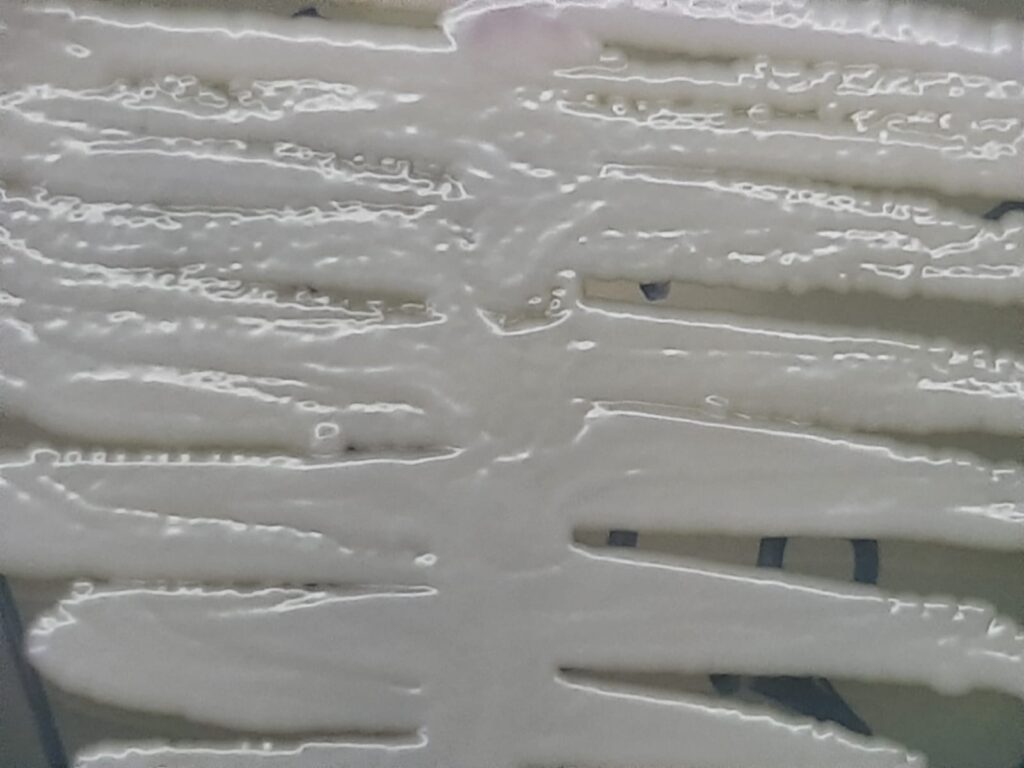
Nakaseomyces glabratus-Introduction, Morphology, Pathogenicity, Lab Diagnosis, Treatment, Prevention, and Keynotes

Nakaseomyces glabratus-Introduction, Morphology, Pathogenicity, Lab Diagnosis, Treatment, Prevention, and Keynotes
Introduction
Nakaseomyces glabratus (formerly Candida glabrata) is a highly adaptable, haploid yeast that is a common commensal of the human gastrointestinal and genitourinary tracts. It is the second or third most common cause of candidiasis worldwide and is notable for its high level of intrinsic and acquired antifungal resistance.
Morphology
- Cellular Structure: Unlike many other Candida species, N. glabratus is nondimorphic, meaning it only exists as small, oval blastoconidia (yeast cells).
- Lack of Hyphae: It cannot form true hyphae or pseudohyphae under typical conditions.
- Genome: It possesses a haploid genome, which allows for the rapid expression of new genetic mutations, contributing to its fast-evolving drug resistance.
Pathogenicity & Virulence
- Adhesion: Expresses a large family of adhesin genes (mostly in subtelomeric regions) that allow it to stick firmly to host tissues and medical devices like catheters.
- Immune Evasion: It can survive and replicate within host macrophages after being engulfed, effectively “hiding” from the immune system.
- Biofilm Formation: Readily forms dense biofilms that act as physical barriers against both host immune cells and antifungal drugs.
- Enzyme Production: Secretes yapsins (aspartic proteases), phospholipases, and lipases that assist in tissue invasion and nutrient acquisition.
Laboratory Diagnosis of Nakaseomyces glabratus
- Culture: Grows well on Sabouraud Dextrose Agar (SDA); on CHROMagar, it typically appears as cream to white, smooth, glistening colonies, as shown in the image (HiCrome Candida Differential Agar).
- Microscopy: Visualization of small (2–5 µm) yeast cells without hyphal structures.
- Biochemical Tests: Uniquely ferments and assimilates only glucose and trehalose.
- Advanced Methods: MALDI-TOF MS and molecular techniques like PCR or MLST are used for rapid and accurate species identification.
Treatment
- Echinocandins (e.g., Caspofungin, Micafungin) are usually the first-line treatment for systemic infections, though resistance is rising.
- Polyenes: Amphotericin B remains highly effective for severe, multidrug-resistant cases.
- Azoles: Fluconazole is often ineffective due to high rates of intrinsic resistance or rapid acquisition of resistance via efflux pumps (e.g., CDR1 gene).
- Topical/Alternative: Boric acid suppositories or nystatin are often used for recurrent vaginal infections.
Prevention
- Antifungal Stewardship: Minimizing the unnecessary use of broad-spectrum antibiotics and azoles to reduce the selection pressure for resistant strains.
- Infection Control: Strict hygiene and proper maintenance of indwelling medical devices (e.g., central lines) in hospital settings.
- Personal Hygiene: Wearing breathable cotton clothing and maintaining good oral health can reduce colonization risk.
Keynotes
- Nosocomial Threat: Increasingly prevalent in ICU settings and among the elderly.
- Genetic Plasticity: Its haploid nature and high frequency of mutations make it a “master of adaptation”.
- Diagnostic Challenge: Often misdiagnosed or overlooked because it is less visually distinct (no hyphae) than C. albicans.
Further Readings
- https://pmc.ncbi.nlm.nih.gov/articles/PMC12531480
- https://www.mdpi.com/1422-0067/26/9/4407
- https://pubmed.ncbi.nlm.nih.gov/39136534
- https://www.nature.com/articles/s41598-025-15577-6
- https://pmc.ncbi.nlm.nih.gov/articles/PMC12205912
- https://cmm.mazums.ac.ir/article_150720.html
- https://mft.nhs.uk/the-trust/other-departments/laboratory-medicine/information-for-gps/laboratory-medicines-newsletter-for-gps/mycology-update-and-gps-qa
- https://www.mdpi.com/1999-4923/13/10/1529
- https://academic.oup.com/femsyr/article/doi/10.1093/femsyr/foaf025/8133892
- https://academic.oup.com/femsle/article/doi/10.1093/femsle/fnaf107/8272672
- https://athenslab.gr/en/diagnostikes-exetaseis/candida-glabrata-molecular-detection-1717
- https://pmc.ncbi.nlm.nih.gov/articles/PMC12072302/
[642 visitors]
